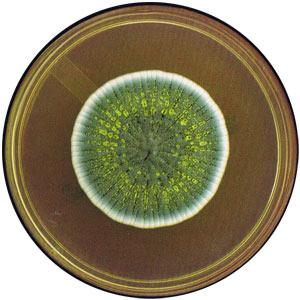
Moho U Hongos. Más Que Un Simple Olor A Humedad.

La gran mayoría hemos dejado un poco de ropa olvidada en la máquina de lavado o bajo la lluvia. Un tiempo después, cuando nos acordamos de tal descuido, vamos a mirar nuestras prendas solo para descubrir que despiden un olor desagradable. Al percibir ese aroma exclamamos sin pensarlo: “ya huele a humedad”.
Pero, ¿en verdad la humedad huele?
En la escuela aprendimos que el agua es un compuesto incoloro, insípido e inodoro. Entonces ¿qué es lo que olemos?
El moho es un hongo que crece tanto al aire libre como en lugares cerrados. La humedad alta, falta de luz y lugares cálidos son factores que favorecen su crecimiento. Estos tres factores se suelen presentar a la perfección en ropa mojada amontonada, alfombras o telas húmedas y hasta en nuestros pies. Estos hongos son de muchos tipos, y algunos crecen formando hifas. Estas hifas producen esporas, que son las “semillas” de los hongos. Las esporas se dispersan por el ambiente y algunas llegan hasta nuestra nariz. Y ahí la pregunta se responde. Lo que en realidad olemos es moho, más concretamente, las esporas de estos mohos.
En realidad el moho que podemos encontrar en casa tiene presente a una gran cantidad de hongos de diversos géneros y especies. Dos de los más comunes, y de los que hablaremos aquí, son Aspergillus y Penicillium.
Aspergillus es un género que reúne cientos de especies de hongos o mohos. Se encuentra naturalmente en la composta o el heno. Algunas especies de este hongo son patógenas, encontrando que son causantes de enfermedades como: aspergilosis, onicomicosis, otomicosis y sinusitis alérgica, entre otras. La onicomicosis es lo que se le conoce popularmente como hongos en las uñas de los pies. Por otro lado, la sinusitis alérgica es lo que se conoce como alergia a la humedad.
Aunque todo esto nos suena a que los hongos son malos, la realidad es que son blanco y negro, tal como nuestras amigas las bacterias.
Una especie de Aspergillus, concretamente Aspergillus niger, se cultiva para producir productos químicos, como ácido cítrico, ácido glucónico, glucoamilasa entre otros. También, recientemente, las esporas de este hongo se han estado usando, con éxito, para adsorber los metales pesados presentes en cuerpos de agua, dando una alternativa más al tratamiento de aguas residuales.
El segundo género mencionado es Penicillium. Quizá el nombre te suene de algo conocido. Se parece mucho al nombre de un antibiótico: la penicilina. Pues es porque este antibiótico es producido por una especie de Penicillium. La especie con la que estaba trabajando Alexander Fleming cuando descubrió el antibiótico: Penicillium chrysogenum.
Además, este hongo lo podemos encontrar en nuestra comida. En naranjas, pan, tortillas, limones, etcétera. Así es, ese recubrimiento blanco que parece algodón y que aparece de pronto en los alimentos que se echan a perder, es moho, y entre sus habitantes está Penicillium.

Pero, una vez más, las bondades de los hongos existen y se cuentan por muchas. Algunas especies de Penicillium se utilizan para fermentar la leche y producir quesos como el roquefort o el camembert. Por ejemplo, el queso camembert se produce usando Penicillium candidium. Y no solo eso, sino que los hongos no son retirados una vez hecho el queso. Así es, al ingerir estos productos también estás ingiriendo los hongos usados para su producción.
En conclusión, en el reino fungi podemos encontrar una gran variedad de hongos y levaduras que pueden ser malas o buenas. Nos pueden ayudar a producir los compuestos para atacar bacterias peligrosas o a producir algunos de nuestros alimentos. O bien, pueden producir compuestos que nos hagan daño o hasta nos liquiden. Este es un mundo que, al igual que el de las bacterias, es muy vasto y lleno de bondades y maldades. Un mundo que vale la pena conocer.
